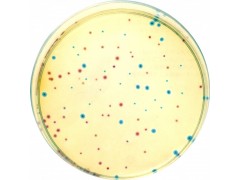

产品简介
CCDA基础CCDA Base产品说明及用途培养基(Medium)是供微生物、植物和动物组织生长和维持用的人工配制的养料,一般都含有培养基
公司简介
上海信裕生物科技有限公司是一家生物高新技术企业,主要从事免疫学、分子生物学和常规生化试剂的研发、销售。并代理销售Amresco,qiagen,GenWay,Sciencell,Millipore,eBioscience,Sigma、R&D、GBD、ATCC、HYCLONE等二十多家国内外知名品牌,致力于为广大高校、科研院所和企业单位提供的科研试剂和完善的技术服务,满足生物化学、分子生物学 、细胞生物学、免疫学 ELISA试剂盒等生物科技实验需求。
上海信裕先后与天津中医学院、复旦大学、上海交通大学医学院、上海交通大学、华东师范大学、第二军医大学、南京大学,暨南大学,南京工业大学,曙光医院、华山医院、瑞金医院、上海有机研究所、中科院上海分院等多家单位建立了良好的合作关系。本公司可为您提供科研ELISA试剂盒,种属标本齐全,有专门针对人血清、血浆、全血、分泌物、尿液、细胞培养上清液、组织匀浆、组织液等标本的试剂盒;另有针对各种动物(鼠、兔、牛、马、鸡、猪、狗、山羊、猴、鱼)的科研试剂。
公司秉承“专注品质、信守承诺、积极沟通、创新服务”的企业文化积极参与生物领域的技术创新和技术服务,力求为我国科研事业,专业的服务!
其主营产品:ELISA试剂盒/人ELISA试剂盒/大鼠ELISA试剂盒/小鼠ELISA试剂盒/金标试剂盒/免疫组化试剂盒/标准品/科研抗体/生化试剂,生物培养基/细胞株/实验室耗材/动物血清等科研产品
展开
产品说明
CCDA基础
CCDA Base
产品说明及用途
培养基(Medium)是供微生物、植物和动物组织生长和维持用的人工配制的养料,一般都含有培养基有碳水化合物、含氮物质、无机盐(包括微量元素)以及维生素和水等。有的培养基还含有抗菌素和色素。
【一般贮存】必须防潮、避光、阴凉处保存
【组织培养基贮存】较长时间的贮存,必须放在2~6℃的冰箱内
【注意事项】:由于液体培养基不易长期保管,现在均改制成粉末。
CCDA基础
CCDA Base
产品展示:
30210 麦康凯琼脂培养基(MacC)平板 90mm×10 个/包 95 用于大肠菌群测定
30310 沙门、志贺菌属琼脂培养基(SS)平板 90mm×10 个/包 95
用于沙门氏菌、志贺氏菌
选择性分离
30506 四号琼脂平板 90mm×10 个/包155 霍乱弧菌选择性分离
8
30507 庆大霉素琼脂平板 90mm×10 个/包130 霍乱弧菌选择性分离
一次性试管、液体培养基
编号 产品名称 规格 价格(元) 用途
30202 无菌煌绿乳糖胆盐(BGLB)肉汤 9ml×20 支/盒 180 含倒管,大肠菌群测定
30207 无菌MUGal 肉汤(含头孢磺啶) 10ml×20 支/盒335 用于大肠菌群快速检测
30301 无菌缓冲蛋白胨水(BPW) 225ml×12 瓶/箱140 用于沙门氏菌前增菌
30302 无菌四硫磺酸钠煌绿(TTB)增菌液 10ml×20 支/盒180 沙门氏菌选择性增菌
30303 无菌亚硒酸盐胱氨酸(SC)增菌液 10ml×20 支/盒180 沙门氏菌选择性增菌
30401 无菌GN 增菌液 225ml×12 瓶/箱140 用于志贺氏菌增菌
30203 无菌营养肉汤 225ml×12 瓶/箱140 用于细菌的增菌
30204 无菌乳糖胆盐发酵管 10ml×20 支/盒240 含倒管,大肠菌群测定
30206 克氏双糖铁琼脂(KI)斜面 20 支/盒 120
用于肠道菌的复合生化
试验
30501 无菌3%氯化钠碱性蛋白胨水 225ml×12 瓶/箱215 用于副溶血性弧菌增菌
30502 无菌3%氯化钠碱性蛋白胨水 9ml ×20 支/盒120 用于副溶血性弧菌增菌
30505 3%氯化钠三糖铁琼脂斜面 20 支/盒 120
用于副溶血性弧菌生化
试验
30601 改良磷酸盐缓冲液 225ml×12 瓶/箱240
用于小肠结肠炎耶尔森
氏菌增菌
30801 无菌7.5%氯化钠肉汤 225ml×12 瓶/箱120
用于金黄色葡萄球菌的
均质增菌
30805 无菌脑心浸出液肉汤(BHI) 5ml×20 支/盒 180 用于细菌的培养
30802 10%氯化钠胰酪胨大豆肉汤 225ml×12 瓶/箱140
CCDA基础
CCDA Base
本页产品地址:http://www.geilan.com/sell/show-1990388.html

![]()
 免责声明:以上所展示的[ CCDA基础]信息由会员[上海信裕生物科技有限公司]自行提供,内容的真实性、准确性和合法性由发布会员负责。
免责声明:以上所展示的[ CCDA基础]信息由会员[上海信裕生物科技有限公司]自行提供,内容的真实性、准确性和合法性由发布会员负责。